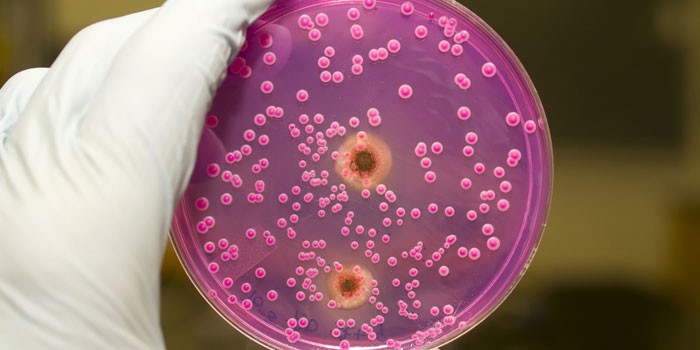

Появление тревожных симптомов требует принятия срочных мер – обращения к врачу. Если у женщины при анализах в мазке обнаружили псевдомицелий, – это сигнал, что в организме начинает активное размножение дрожжеподобный грибок кандида. Какими симптомами характеризуется инфекция, почему она возникает, как бороться с возбудителями болезни – ответы на вопросы полезно знать всем, желающим сохранить свое здоровье.
Что такое грибок кандида
Организм человека населен огромным количеством бактерий, которые помогают ему правильно функционировать. Когда нет проблем со здоровьем, все они находятся в балансе. Candida albicans – один из этих микроорганизмов – обитает в нормальной микрофлоре кишечника, на слизистой оболочке влагалища, полости рта. Так он выглядит на фото. Эти патогенные микроорганизмы:
- круглой формы;
- размером около 10 микрон;
- живут при температуре до 37 градусов;
- имеют стойкость к неблагоприятным условиям.
Когда по каким-либо причинам в организме происходит снижение иммунитета, начинается бурный рост дрожжевых грибков. Нормальная микрофлора при этом нарушается. Такая ситуация вызывает:
- развитие кандидоза – молочницы;
- поражение ногтей;
- распространение инфекции в полости рта;
- воспаление слизистых оболочек кишечника;
- заболевание органов дыхания, нервной системы.
Как передается
Главная опасность кандидоза – инфекция распространяется с большой скоростью. Кандида быстро поражает слизистые оболочки всего организма. Грибковое заболевание передается половым путем при незащищенном сексе. Возможно заражение через:
- продукты питания;
- постельное белье;
- предметы быта;
- плохо вымытые фрукты, овощи;
- поцелуи;
- игрушки;
- прокладки;
- предметы личной гигиены.
Дрожжеподобный грибок может попасть в организм при медицинском вмешательстве во время гинекологического, стоматологического осмотра с плохо обработанным инструментом. Кандида альбиканс передается:
- от женщины ребенку при родах;
- воздушно-капельным путем;
- новорожденным через плохо простиранные пеленки;
- при пользовании чужими предметами, одеждой.
Симптомы кандидоза
Что такое кандидоз? Это инфекционное заболевание, спровоцированное быстрым размножением дрожжеподобных грибков. Патология сопровождается симптомами, зависящими от дислокации поражения. У больных кандидозом наблюдаются:
- грибок ногтей;
- поражения кожи;
- боли в мышцах;
- диарея;
- повышенное газообразование;
- заложенность носа;
- высыпания на оболочке ротовой полости;
- покраснения половых органов;
- головные боли.
Грибковое заболевание кандидоз зачастую имеет симптомы, схожие с другими недугами:
- кандида в кишечнике провоцирует ухудшение аппетита, тяжесть в животе, вкрапления в стуле, похожие на творог;
- рост cand >
У женщин
Патогенные микроорганизмы рода кандида воздействуют на слизистую влагалища, вызывая опасное и тяжелое заболевание. Что такое молочница у женщин? Это инфекция наружных и внутренних половых органов, вызванная патогенной микрофлорой, жизнедеятельностью грибка. Факторы, которые способствуют разрастанию кандида:
- отсутствие нормального иммунитета;
- аллергические заболевания;
- прием контрацептивов;
- употребление пищи, содержащей дрожжи, сахар;
- лечение антибиотиками вирусов;
- хронические заболевания ЖКТ;
- сахарный диабет.
Когда развивается молочница, у женщины наблюдаются такие признаки поражения кандида:
- боль и жжение во время секса;
- нарушения менструации;
- творожистые выделения из влагалища;
- болезненность при мочеиспускании;
- появление специфического кефирного запаха;
- снижение сексуального влечения;
- раздражение половых органов;
- болевые ощущения в тазовой области;
- бесплодие.
У мужчин
От активности грибка страдают и мужчины. Этому способствуют токсины, образующиеся как продукты жизнедеятельности бактерий. Кандида поражает кожу, воздействует на половые органы. У мужчин наблюдаются признаки молочницы, схожие с женскими симптомами:
- боли при мочеиспускании;
- появление сыпи, белесого налета на половом органе;
- образование папул.
Грибок рода кандида поражает кожу в области паха. О наличии инфекционного заболевания у мужчин свидетельствуют:
- воспаление, покраснение головки пениса;
- возникновение сыпи;
- образование пузырьков;
- болезненность при половом акте;
- нестерпимый зуд;
- ощущение жжение;
- развитие простатита;
- появление импотенции;
- снижение полового влечения.
Классификация
При обнаружении псевдомицелий в анализах, в зависимости от скорости размножения грибков, тяжести недуга, различают виды кандидоза:
- поверхностный – начальная стадия – поддается лечению, патогенные бактерии действует ткани кожи, ногти, слизистую;
- системный вид – проникает в эпителий, способен поражать систему дыхания, органы пищеварения;
- сепсис – состояние, при котором кандида обнаруживается в крови, отравляет весь организм, не исключен летальный исход.
Существует классификация кандидоза в соответствии с формой грибкового заболевания:
- Острая – имеет ярко выраженные симптомы, при своевременной диагностике быстро вылечивается. В запущенном состоянии называется махровой, заражает эпителиальные ткани.
- Хроническая – появляется при неправильном лечении, отсутствии чувствительности к препаратам.
- Кандидоносительная – анализы показывают наличие огромного количества кандида без внешних проявлений болезни. Человек является носителем грибка, может заражать окружающих.
Осложнения кандидоза
Если своевременно не заняться лечением инфекции, дрожжеподобные грибы кандида прорастают вглубь организма, поражают сосуды, попадают в кровь. После этого идет распространение патогенных микроорганизмов по всему организму. При этом наблюдается:
- появление новых очагов болезни;
- развитие кровотечений;
- нарушение половых функций;
- распространение инфекции на соседние органы.
Разрастание грибков при отсутствии лечения вызывает:
- прерывание беременности;
- заражение плода при родах;
- поражение органов пищеварения;
- возникновение аллергических реакций;
- нарушение работы почек;
- воспаление мочевого пузыря;
- бесплодие;
- появление спаек во влагалище;
- поражение шейки матки, провоцирующее рак;
- развитие гнойных инфекций;
- летальный исход.
Можно ли применять Вагинорм С от молочницы
Многие годы безуспешно боретесь с МОЛОЧНИЦЕЙ?
Глава Института: «Вы будете поражены, насколько просто можно вылечить молочницу принимая каждый день.
Можно ли применять Вагинорм от молочницы? Сегодня этот вопрос волнует многих женщин. Гинекологи нередко назначают своим пациенткам Вагинорм С в составе комплексного лечения вагинального кандидоза и для профилактики рецидива грибковой инфекции. Отзывы о действии данного препарата очень противоречивы: многие женщины признаются, что средство не только не помогло избавиться от молочницы, но и спровоцировало усиление симптомов заболевания. Споры об эффективности Вагинорма не утихают уже долгое время. Так как же действует препарат и может ли он вылечить кандидоз?
Помогает ли препарат при молочнице?
Вагинорм С — вагинальные таблетки, главным действующим веществом которых является аскорбиновая кислота. В первую очередь данный препарат предназначен для нормализации микрофлоры влагалища. Витамин С, входящий в состав Вагинорма, благотворно влияет на слизистую женских половых органов. Он улучшает синтез гликогена — вещества, необходимого для роста полезных лактобактерий. Получая достаточный объем питания, лактобациллы начинают активно размножаться, а в процессе их деятельности образуется кислота, нормализующая влагалищную микрофлору. Кислая среда губительна для многих видов патогенных бактерий — стафилококков, стрептококков, гарднерелл и пр. Такое действие Вагинорма позволяет успешно использовать его в терапии бактериального вагиноза, в том числе хронического.
Также препарат эффективно устраняет дисбактериоз влагалища, возникающий после кандидоза и применения антимикотических средств. Однако при молочнице Вагинорм оказывает прямо противоположное действие: резкое изменение микрофлоры влагалища провоцирует рост грибков и приводит к развитию кандидозного вульвовагинита. Таким образом, препарат не только не способен вылечить молочницу, но и может привести к обострению заболевания. Тем не менее Вагинорм С действительно назначают на конечном этапе противогрибковой терапии, когда рост патогенной флоры подавлен и инфекция уже устранена при помощи антимикотических препаратов. Средство помогает в короткие сроки восстановить нормальную среду во влагалище, укрепляет и регенерирует слизистую оболочку, а также повышает местную защиту, снижая риск возникновения рецидива кандидоза.
Как использовать средство
Негативные отзывы о Вагинорм в большинстве случаев связаны с неправильным применением этих вагинальных таблеток. При лечении данным препаратом необходимо придерживаться следующих правил:
- Так как Вагинорм С при молочнице использовать противопоказано, перед началом лечения дисбактериоза влагалища необходимо обязательно сделать анализ на микрофлору, чтобы исключить наличие дрожжевых грибков, провоцирующих развитие кандидоза. Если патогенные микроорганизмы этого типа присутствуют в мазке даже в небольшом количестве, проводить терапию с использованием Вагинорма нельзя. Прежде всего следует до конца вылечить молочницу.
- Если молочница началась во время применения Вагинорма, использование препарата следует временно прекратить — до тех пор, пока не будут устранены симптомы кандидоза. Затем восстанавливающую терапию нужно продолжить.
- Проводить лечение средством необходимо не менее 6 дней. По назначению врача длительность терапии может быть увеличена до 10 суток.
- Вводить вагинальные таблетки Вагинорм С рекомендуется перед сном. Вставлять суппозитории во влагалище лучше всего в положении лежа, для облегчения введения предварительно окунув их в чистую воду.
- Менструация, а также обильные слизистые выделения, не связанные с развитием молочницы, не являются показанием к прерыванию терапии.
Вагинорм С не обладает противогрибковой активностью и не может быть использован для лечения молочницы. Однако это средство успешно применяют в качестве восстанавливающей терапии после перенесенной кандидозной инфекции. Препарат считается одним из самых безопасных и эффективных медикаментов, предназначенных для нормализации микрофлоры влагалища, и при правильном использовании приносит действительно хорошие результаты.
Что будет, если не лечить молочницу? Можно ли это допускать?
Остановимся на вопросе: что же такое, вообще, молочница? Вульвовагинальный кандидоз представляет собой заболевание инфекционной природы, поражающее слизистую влагалища, распространяющееся на шейку матки и вульву, вызванное грибами рода Candida, а в частности C.albicans.
Кроме того, заболевание могут вызывать грибы рода Torulopsis как самостоятельно, так и в ассоциации с Canida albicans. Они имеют округлую вытянутую форму в виде розетки, а иногда и неправильную форму, образующие цепочку, называющуюся псевдомицелии.
Размножаются клетки путем многополюсного почкования, когда от «материнского организма» образуются 2-3 дочерние клетки.
Где обитают? Грибы Candida можно обнаружить на коже, а также слизистых рта, кишечника, влагалища. Эти микроорганизмы можно обнаружить у здоровой части женского населения, у обследованных беременных в 3-5%.
Виды кандидоза
Различают вульвовагинальный кандидиоз неосложненный и осложненный.
Для неосложненного ВВК характерно:
1. Легкая или умеренная тяжесть вагинита.
2. Менее 4-х эпизодов в год.
3. Возбудитель Candida albicans.
4. Нормальное состояние иммунной системы.
Для осложненного ВВК характерно:
1. Тяжелое течение.
2. Более 4-х эпизодов в год.
3. Возбудитель Сandida non-albicans.
4. Иммунокомпрометированные состояния (беременность, сахарный диабет в стадии декомпенсации).
Пути заражения
Заражение грибами происходит путем контакта с больными и кандидоносителями, а также в результате элиминации возбудителя из кишечника; через инфицированные предметы. К одним из путей заражения также относится и половой путь, но он не является основным.
Кроме того, причинами развития молочницы могут являться состояния сниженного иммунитета, гормональные нарушения, а также нарушения обмена белков, углеводов, витаминов; хронические заболевания, такие, как сахарный диабет, туберкулез, сальпингит, болезни органов пищеварения и многие другие.
Еще к причинам развития молочницы можно отнести состояния после лечения антибиотиками, кортикостероидными гормонами, иммунодепрессантами, когда развивается дисбактериоз, что усиливает размножение грибов.
По уровню поражения половых путей различают кольпит, цервицит, вульвит. В состоянии иммунодефицита грибы вызывают воспалительную реакцию, путем проникновения в эпителий и внедрения в него.
В тяжелых, запущенных случаях, возможно распространение возбудителя кандидоза в глубокие слои эпителия.
У кого чаще?
Вульвовагинальный кандидоз можно встретить в разных возрастных категориях, но в основном это женщины репродуктивного возраста, пациентки гинекологических и венерологических стационаров, у которых молочница встречается в комплексе с другими инфекциями.
Основные проявления
Клиническая картина генитального кандидоза представлена, в основном выделениями (бели) и зудом в области половых органов, однако, не всегда бели свидетельствуют о вульвовагинальном кандидозе (в трети случаев диагноз не подтверждается). Поэтому подтвердить диагноз вульвовагинального кандидоза можно только обнаружением возбудителя.
По характеру выделения могут быть обильными жидкими, творожистыми, либо густыми, мазеподобными, зеленовато-белого цвета с неприятным кисловатым запахом.
Одним из частых симптомов при молочнице, особенно при поражении вульвы, является интенсивный зуд, который может быть непостоянным, беспокоить во второй половине дня, вечером и ночью, что очень часто приводит к нарушению сна и, в итоге, к расстройству нервной системы.
Кроме того, зуд может усиливаться во время движений и во время менструации. В запущенных случаях зуд и жжение при мочеиспускании могут вызвать задержку мочи и инфицирование мочевых путей.
В легкой стадии заболевания основной жалобой является зуд. Одним из характерных признаков при вульвовагинальном кандидозе являются налеты на слизистых оболочках вульвы, влагалища и шейки матки, серовато-белого цвета.
В зависимости от того какая стадия кандидоза, слизистая оболочка имеет особенности. В острой стадии заболевания гиперемированная, отечная и налеты удаляются с трудом, в хронической стадии слизистая без изменений и налеты снимаются легко.
После удаления налетов отмечается сильно гиперемированная слизистая оболочка, нередко кровоточащая. При выраженном кандидозе такие изменения образуются в области малых и больших половых губ, клитора, а также вокруг наружного отверстия уретры.
Что будет, если не лечить?
При нелеченности острого периода кандидоза он может перейти в хроническую стадию, когда симптомы заболевания не выражены, так как при острой стадии, но достаточно назойливы, чтобы омрачить жизнь.
Хронический кандидоз — это заболевание, которое может протекать довольно долгие месяцы и годы, а обострения могут быть во время менструаций или сопровождать сопутствующую патологию.
Подтверждение диагноза
Диагностика вульвовагинального кандидоза сводится, прежде всего, к клинической картине заболевания, а именно: зуд, бели, характерные налеты и другие, выявляемые в ходе обследования женщины.
Однако, точный диагноз выставляется после проведения специального обследования. Проводится микроскопия вагинального мазка, где обнаруживаются споры и мицелий грибов.
В остальном мазок может содержать любую флору, любое количество лейкоцитов и лактобактерий или ключевых клеток, поскольку кандида – это универсальный микроорганизм, который способен существовать и в кислой, и в щелочной среде. Но не всегда на практике клиническая картина коррелирует с лабораторной.
Нередко наблюдается картина вагинального кандидоза, но по результатам мазка грибок не обнаруживается и наоборот. Отсутствие кандиды в лабораторных тестах при наличии симптомов – показание к терапии!
Чувствительность микроскопии 10*5КОЕмл (обнаруживается грибок только при этой и выше концентрации), тогда как клинические симптомы возникают уже при концентрации 10*3 КОЕмл. И напротив, обнаружение кандиды в мазках, но отсутствие симптомов не служит показанием к терапии!
Существуют методы диагностики, к которым относятся метод посева биоматериала на питательную среду с дальнейшим изучением полученной культуры; серологические методы.
Существуют также другие методы диагностики кандидоза: Аллергическая кожная проба, которая применяется при диаметре папулы и эритемы 0.5-1.0 см.; метод серологических реакций; гистологическое исследование, которое применяется при отсутствии точных результатов других методов исследования.
Начинаем лечение
Лечение неосложненного ВВК:
- Флуконазол (Дифлюкан, Флузол, Флунол, Дифлюзол) 150 мг однократно или местные препараты длительно. Ответ на терапию 80-90%. Эффективность недельного местного лечения сопоставима с эффективностью однократного приема Флуконазола, однако, важно помнить, что местное лечение не рекомендуется проводить во время менструации и местные препараты могут повреждать презервативы.
- Нистатин представлен в виде свечей по 250 000 и 500 000 Ед, которые вводятся в задний свод влагалища 1-2 раза в день в течении 10-14 дней.
- Можно использовать Клотримазол в виде крема 1%( наносить крем на слизистые оболочки ), а также Клотримазол в виде вагинальных таблеток ,которые вводятся в задний свод влагалища на ночь.
- Пимафуцин – активным веществом которого является натамицин с широким спектром действия, по 1 вагинальной таблетке(0,025 г) 2 раза в день в течении 10 дней или использование его в форме крема (1 г содержит 0,02 активного вещества) 2 раза в день в течении 10 дней.
- Тержинан это комбинированный препарат, используемый в гинекологии, высокоактивен в отношении грибов рода Candida, по 1 таблетки во влагалище перед сном, предварительно смочив ее в воде, 10-20 дней.
Лечение осложненного ВВК:
Местное лечение азолами 7-14 дней. Или Флуконазол внутрь по 150 мг 2 раза с интервалом в 72 часа. Если обострений менее 4-х в год, каждый рецидив лечится как отдельный эпизод.
Лечение рецидивирующего ВВК. Цель лечения — добиться устранения симптомов и микологической эрадикации, купируя рецидив. Поддерживать отсутствие роста при помощи супрессивной поддерживающей противорецидивной терапии –назначение 3 таблеток Дифлюкана с интервалом в 72 часа, а затем поддерживающая терапия через 14 суток.
Терапия рецидивирующего ВВК, вызванного candida non-albicans. К сожалению, оптимального лечения не существует. В 50% случаев симптоматика минимальна или отсутствует вовсе. Требуется более длительный курс азоловыми антимикотиками (7-14 дней), но не флуконазолом. Борная кислота в желатиновых капсулах (70% эрадикации). Свечи Нистатин, Амфотерицин.
Терапия ВВК при беременности. Не следует использовать пероральные препараты! До 12 недель разрешен натамицин в свечах 1 раз в сутки 3-6 дней. После 12 недели – азоловые местные препараты.
Альтернативные способы профилактики рецидивов ВВК. Применение препаратов, содержащих молочнокислые бактерии возможно, но отсутствуют исследования, доказавшие эффективность такой терапии.
Лечение партнеров женщин с выделениями из влагалища. Обязательно, при наличии ИППП. Необязательно при БВ и ВВК, но показано при кандидозном баланите и баланопостите (флуконазол 150 мг однократно). Нецелесообразно лечение партнеров с целью профилактики рецидивов у пациентки при отсутствии у них клиники.
Почему не вылечилась уреаплазма: повторное лечение после
«Как ведет себя уреаплазма после лечения?», «Почему уреаплазма не вылечивается?» подобными вопросами пестрят медицинские форумы в сети. Многие больные с данным диагнозом, потерпевшие неудачу в первичном курсе терапии, призывают людей не обращаться к врачам, давая советы из личного опыта. Правильно это или нет – каждый принимает решение самостоятельно. Но чтобы сделанный выбор не привел к непоправимым последствиям нужно располагать информацией об этом недуге.
Уреаплазма – инфекция, в большинстве случаев передающаяся половым путем (ИППП) и наиболее часто встречающаяся у женщин. Медицинская статистика утверждает, что мужчины и девочки значительно реже инфицируются этими клеточными паразитами с условно-патогенной флорой.
Возбудитель инфекции, обнаруженный в мазке, не всегда нуждается в лечении. Но если вы планируете в ближайшее время беременность или на лицо болезненные симптомы, а показатель посева выявил количество микробов более 104 КОЕ/мл, то лекарственная терапия необходима.
Уреаплазмоз после лечения довольно часто рецидивирует, это объясняется индивидуальными особенностями мельчайших возбудителей, способных прикрепляясь к мембранам клетки, укрываться от защитных функций иммунитета и химической атаки антибиотиков. Поэтому избавиться от колоний цитопаразитов, обитающих на слизистых мочеполового тракта, достаточно сложно.
Также заявляя, что уреаплазма не вылечилась с первого раза, многие пациенты не уточняют, как проводился курс терапии и насколько ответственно они выполняли рекомендации лечащего врача. А ведь существует множество причин, способных влиять на тот факт, что уреаплазма после лечения снова будет обнаружена в мазке и потребуется повторное лечение уреаплазмоза. Некоторые из них:
- Не полный курс антибиотиков. Схема терапии данной ИППП достаточно сложная и дорогостоящая. По причине того, что лекарство принималось не регулярно (пропускается прием антибиотика, меняется дозировка) или из-за финансовых затруднений был пропит не полный курс таблеток, уреаплазмоз после лечения проявится вновь и потребуется повторный курс терапии;
- Половые контакты без барьерной контрацепции с инфицированным партнером, который не прошел или не завершил курс лечения. Терапию необходимо получать обоим половым партнерам, даже в том случае если у мужчины нет симптомов болезни. Иначе после выздоровления в скором времени вновь понадобится повторное лечение уреаплазмы. Данная инфекция не вырабатывает устойчивого иммунитета.
- Устойчивость патогенов к используемым лекарственным препаратам.
Если уреаплазма после лечения в том же количестве обнаруживается в мазке, то первичный курс терапии по той или иной причине не дал ожидаемого результата. Соответственно назначается повторное лечение уреаплазмоза. Врач подбирает более сильный антибиотик, ведь к первому лекарству инфекция уже адаптировалась, и оно не имеет никакого действия на паразитов. Повторное лечение уреаплазмы в большинстве случаев предусматривает комплекс-подход, куда помимо антибиотиков входит прием иммуномодуляторов и физиотерапевтические процедуры. Если и после повторного курса назначенных препаратов инфекция не вылечилась, но воспалительный процесс исчез, то врач оставит пациента под наблюдением, закончив прием лекарств.
https://youtube.com/watch?v=_CXyjMX_v_s
Молочница считается распространенным недугом, который поражает как женщин разных возрастов, так мужчин и детей. Следовательно, нужно знать, как связаны молочница и споры. Молочница, вызванная грибами рода Candida, — заболевание, проявляющееся на разных участках кожи и слизистых на теле человека. Чаще обнаруживается на половых органах. Когда на приеме у гинеколога девушек был взят мазок, результат анализа может указать на наличие дрожжевых спор или мицелия (тела) грибков в смазке. В таком случае пациенту ставят диагноз «молочница».
ВАЖНО ЗНАТЬ! Даже «запущенный» грибок можно вывести дома, без операций и больниц. Просто прочитайте что сделала Надежда читать рекомендацию.
Что значит споры в мазке?
Гинеколог берет мазок, и микроскопическим методом определяют наличие мицелий гриба. Если их количество превышает норму, то будет поставлен диагноз «вагинальный кандидоз». Стоит помнить, что эти грибки находятся в организме человека постоянно, но вызывают молочницу лишь под воздействием определенных факторов. Если в мазке обнаружены споры, значит, человек является носителем дрожжеподобного грибка Кандида.
Почему появляются споры?
На развитие молочницы влияют определенные факторы. Часто она возникает именно у беременных женщин. При вынашивании плода уровень женских половых гормонов увеличивается, что приводит к изменению микрофлоры влагалища. В итоге создаются условия для роста и размножения грибка, а физиологически ослабленный иммунитет, силы которого брошены на защиту эмбриона, не способен сдержать развитие грибковой инфекции.
Основными причинами появления грибковых спор, а потом и урогенитальной молочницы, считается:
- постоянное ношение тесного белья;
- гормональный сбой;
- изменение диеты;
- стресс;
- долгий прием антибиотиков;
- переохлаждение;
- беременность.
Вернуться к оглавлению
Опасны ли споры в мазке?
Наличие спор молочницы в мазке говорит о высоком риске развития молочницы, так как именно из них растут сами грибы при малейшем снижении иммунитета. Если больного постоянно беспокоят основные симптомы кандидоза, такие как жжение, зуд и боль, значит, недуг уже перешел в активную фазу и началось воспаление тканей. Если вовремя не приступить к лечению клетки теряют прочность, что способствует травматизации слизистых влагалища при выполнении ежедневных гигиенических процедур или во время родов. Активное образование спор в мазке указывает на снижение иммунитета, причиной которого может стать и другое, более опасное заболевание, например, ВИЧ. Поэтому консультация врача необходима.
Возможные симптомы
Распознать молочницу возможно по некоторым симптомам, но болезнь может протекать и бессимптомно. Дифдиагностика ранних стадий осложнена схожестью с другими инфекционными заболеваниями. Возможными симптомами являются:
- наличие творожистых выделений;
- зуд, жжение и покраснение половых органов;
- боль во время полового акта;
- налет белого цвета на половых органах;
- боль при мочеиспускании.
Вернуться к оглавлению
Какое лечение применять?
Вылечить молочницу нелегко. Зачастую недуг возвращается спустя какой-то промежуток времени, в частности, при повторном снижении иммунитета. Препараты от грибка делятся на 2 вида: местные и системные. В тяжелых случаях, при запущенном заболевании медики предпочитают второй вид лечения. Принятие таблеток влияет на основной очаг грибков. Местные препараты включают в себя свечи и различные лечебные кремы. Их эффективность меньше, так как они снимают местные симптомы кандидоза, что актуально на первых стадиях. Для лечения одних таблеток и мазей недостаточно, важно устранить провоцирующий фактор появления молочницы.
Важны и профилактические меры, что предупредят рецидив кандидоза. Нужно выбирать свободное белье, меньше нервничать и не принимать антибиотики длительными или частыми курсами, изменить рацион. На время лечебной диеты полностью исключить алкоголь. Из диетического меню убрать продукты, содержащие дрожжи, сыры, консервы и сладкое (обязательно). Количество свежих несладких овощей и фруктов (но не винограда), рыбы и чеснока стоит увеличить в рационе. Изредка можно позволить себе кисломолочные продукты. Важно пить больше воды.